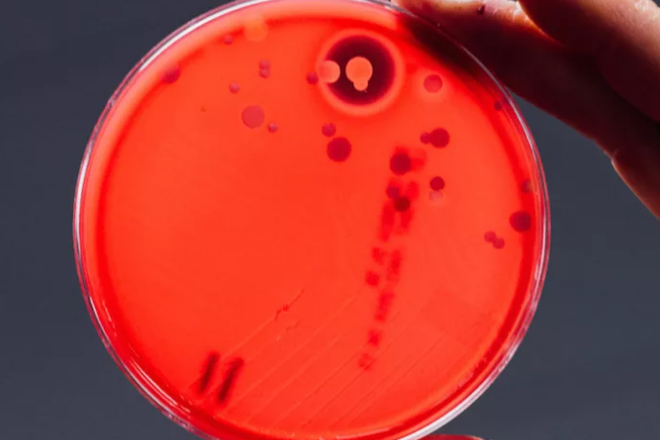
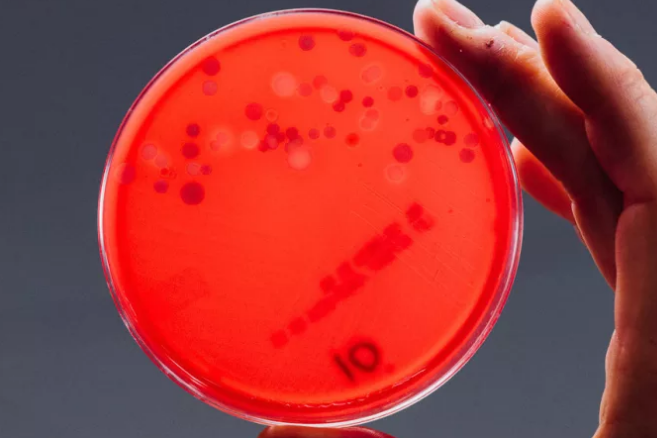
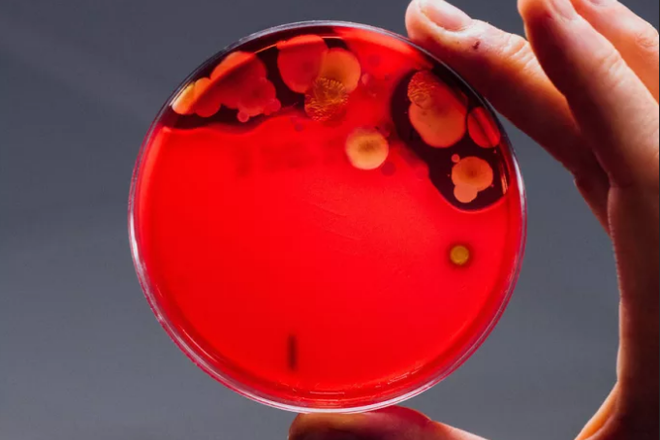

Vi khuẩn và virus có thể tồn tại ở bất cứ đâu xung quanh chúng ta. Có những vi khuẩn vô hại và những vi khuẩn mang theo mầm bệnh. Trên điện thoại của chúng ta ngay lúc này cũng có thể có một số các loại vi khuẩn dưới đây.
Để cho thấy chiếc điện thoại bạn vẫn mang bên mình hàng ngày bẩn tới mức nào, trang BuzzFeed đã thực hiện một thử nghiệm vui với hai mươi chiếc điện thoại của một số người dùng bất kì. Dưới đây là những gì họ tìm thấy.
Hãy bắt đầu bằng những vi khuẩn vô hại. Hầu hết điện thoại được thử nghiệm đều có chứa 5 loại vi khuẩn đến từ da, miệng, mũi và môi trường dưới đây.
- Staphylococcus epidermidis: Vi khuẩn Staphylococcus epidermidis tồn tại trên da con người và hiếm khi gây bệnh đối với người khỏe mạnh. Đây là loại vi khuẩn nhiều khả năng có trên điện thoại từ việc sử dụng hàng ngày như khi bạn chạm vào máy hoặc nghe điện thoại.
- Micrococcus: Vi khuẩn Micrococcus cũng có thể dính lên điện thoại nếu máy chạm vào mặt của bạn hoặc bạn nói chuyện điện thoại nhiều bởi đây cũng là một trong những loại vi khuẩn trên da con người, đặc biệt là trên khuôn mặt.
- Streptococcus viridans: Vi khuẩn Streptococcus viridans sống trong miệng hoặc cổ họng con người. Vì thế, nó có thể có mặt trên điện thoại từ những thao tác như nói chuyện điện thoại hay dính từ tay người dùng trước đó có chạm lên môi hay che miệng khi ho. Trong hầu hết mọi trường hợp, vi khuẩn Streptococcus viridans là vô hại. Tuy nhiên, ở mức độ cao và đối với những người nhạy cảm, chúng cũng có thể gây ra các vấn đề về sức khỏe.
- Moraxella: Đây là vi khuẩn đến từ xoang và thường được tìm thấy trong những người bị viêm xoang hay viêm mũi dị ứng. Mặc dù có thể gây ra các vấn đề ở trẻ em hay những người có sức đề kháng yếu, Moraxella vẫn được xem là một vi khuẩn "thông thường" trên điện thoại.
- Bacillus: Bacillus là một loại vi khuẩn rất hay gặp từ mô trường. Nhiều Bacillus trên điện thoại chứng tỏ máy của bạn rất bẩn nhưng để gây ra bệnh cho người dùng thì không.
Giờ thì hãy cũng điểm danh một số vi khuẩn có chứa mầm bệnh đã được tìm thấy.
1. MRSA

MRSA (tụ cầu vàng kháng methicillin) có thể gây ra nhiễm trùng trên da và môt số cơ quan bên trong cơ thể con người. Nếu không được điều trị kịp thời và ở những người bệnh có sức đề kháng yếu, MRSA thậm chí có thể gây tử vong. MRSA có thể truyền từ người này sang người khác trong một số môi trường, đặc biệt là khi bạn có thể vết thương hở hoặc hệ miễn dịch có vấn đề.
Các chuyên gia cho biết một lượng nhỏ MRSA trên điện thoại khó có thể gây bệnh với những người khỏe mạnh. Tuy nhiên, việc vi khuẩn nguy hiểm này có trên điện thoại cũng rất đáng lo ngại bởi ít nhất nó không phải một vi khuẩn vô hại với con người. MRSA có thể xuất hiện ở một số địa điểm mà người trẻ thường lui tới, sử dụng như các thiết bị tập gym hay phòng thay đồ, vì thế cũng không khó hiểu khi nó có thể dính lên điện thoại.
2. Staphylococcus aureus

Theo nghiêm cứu, một nửa dân số có thể mang vi khuẩn Staphylococcus aureus (tụ cầu vàng) trên cơ thể mà không gặp phải vấn đề gì. Tuy nhiên, điều này cũng khiến nó dễ chuyển từ người này sang người khác một cách dễ dàng và có thể gây ra vấn đề sức khỏe. Nếu Staphylococcus aureus dính vào vết thương hở, ns có thể gây nhiễm trùng và các bệnh về da.
3. E. coli

E. coli là một loại vi khuẩn sống trong ruột của người và động vật và có lẽ nó cũng là vi khuẩn "quen tên" nhất trong số được nhắc đến trong bài viết này. Người nhiễm vi khuẩn E. coli có thể gặp phải một số vấn đề như tiêu chảy, đau bụng, mệt mỏi,sốt, buồn nôn hay chán ăn.
E. coli xuất hiện trên điện thoại có thể là kết quả của việc một người không rửa tay sạch sẽ sau khi đi vệ sinh đã cầm vào điện thoại. Vi khuẩn này cũng là một trong những lý do bạn nhất định không nên mang theo điện thoại vào nhà vệ sinh hay sử dụng máy trong khi ăn.
4. Candida albicans
Một số điện thoại được thử nghiệm cũng có xuất hiện nấm Candida albicans. Loại nấm này có thể gây ra tổn thương đến bộ phận sinh dục, miệng, da hay máu do bệnh thường xuất hiện ở các bộ phận ấm và ẩm ướt trên cơ thể con ngươi. Dù vậy, bạn cũng không nên qua lo lắng bởi các chuyên gia cho rằng lượng nấm Candida albicans trên điện thoại cũng khó có thể gây ra bệnh đối với những người khỏe mạnh.
Giờ thì có thể là bạn đã nghĩ khác về những chiếc điện thoại bóng bẩy mà mình vẫn cầm theo hàng ngày rồi phải không? Hãy nhớ thường xuyên vệ sinh chúng để hạn chế tới mức cao nhất khả năng nhiễm khuẩn nhé!